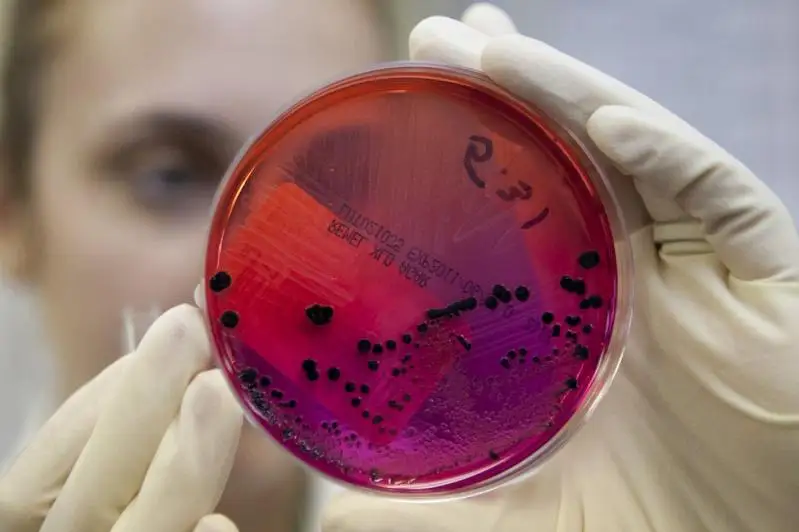
Сибирская язва не подтвердилась у жителя Кокшетау

Авторы


Матасова Оксана
Журналист
Окончила Кокшетауский государственный университет им. Ш. Уалиханова по специальности «Преподаватель русского языка, литературы и английского языка». В разные годы работала корреспондентом и редактором акмолинских газет, на областном телевидении, информационных порталах. С 2017 года корреспондент агентства Kazinform.